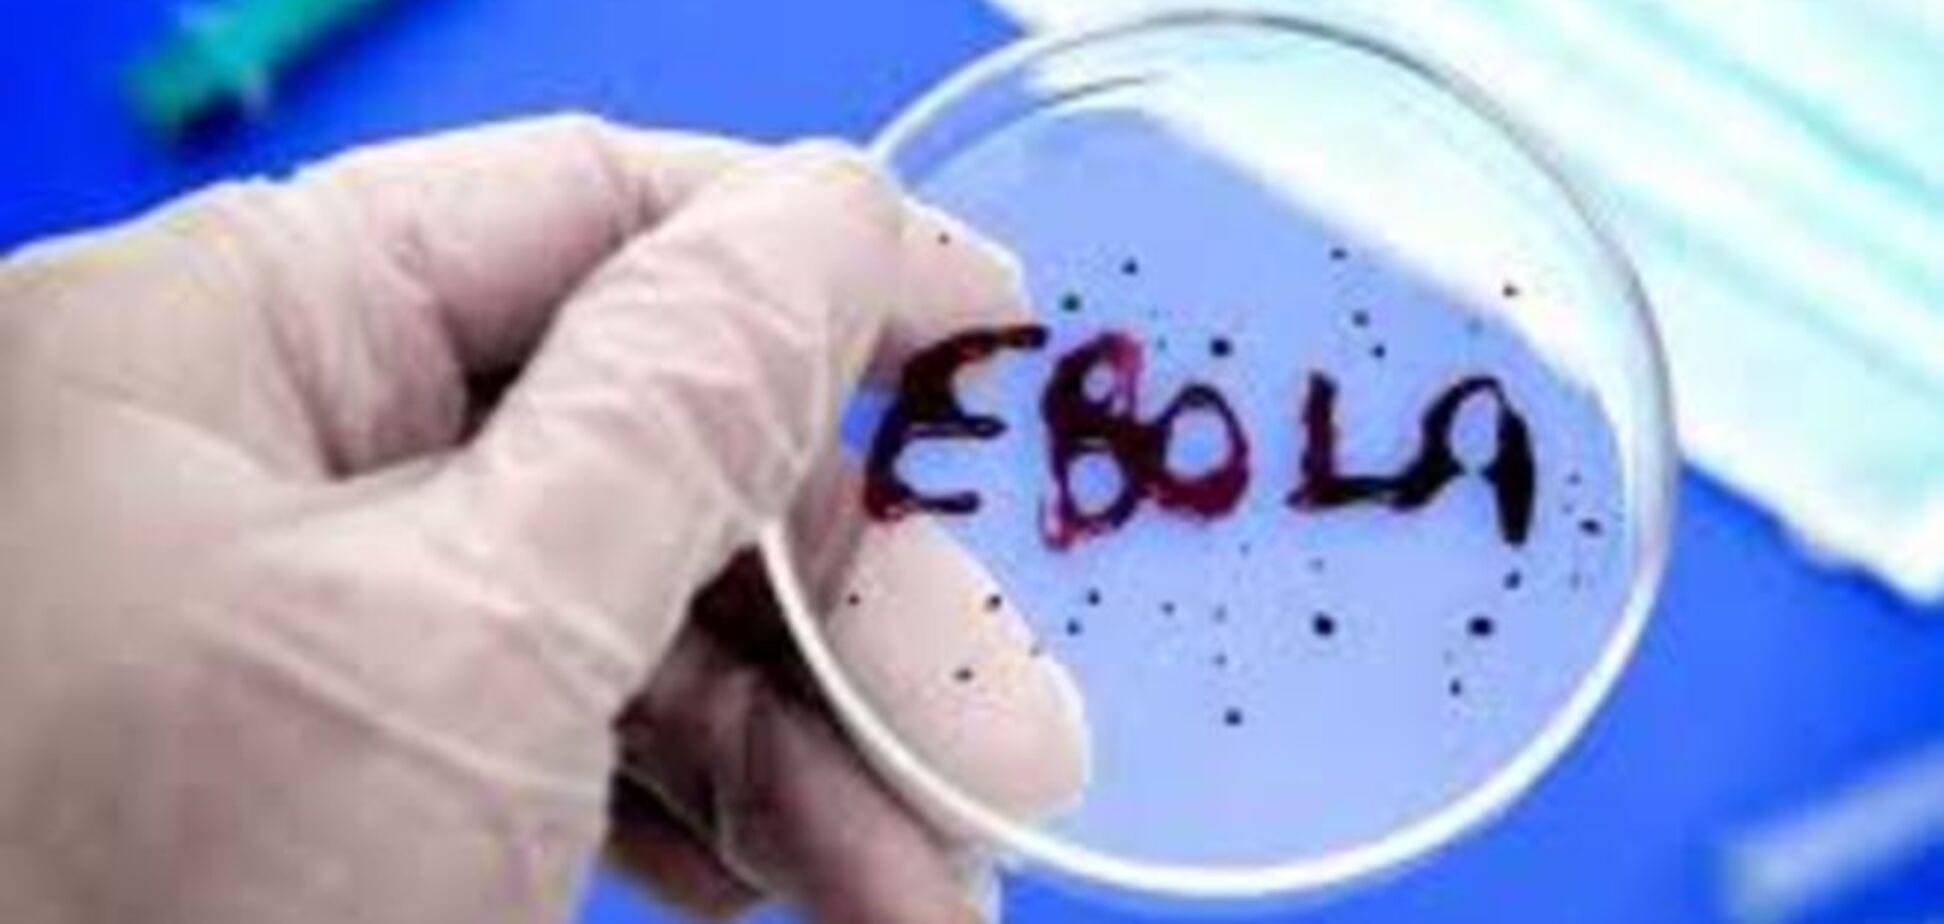
На пути к исцелению: ученые нашли слабое место у вируса Эбола

На пути к исцелению: ученые нашли слабое место у вируса Эбола
В США ученые нашли слабое место у вируса лихорадки Эбола. Так вирусологи выяснили, что для заражения клетки он должен зацепиться за особый белок на поверхности клетки, блокировка которого сделает ее неуязвимой для возбудителя лихорадки.
"В идеале, дальнейшие эксперименты и исследования с участием людей помогут нам создать антивирусные препараты, которые будут цепляться за NPC1 и предотвращать не только заражение Эболой, но и многими другими крайне заразными филовирусами, которые тоже проникают в клетку подобным образом", — заявил Картик Чандран из Иешива-университета в Нью-Йорке, передает РИА Новости.
Чандран и его коллеги смогли найти "ключ", который вирус Эболы использует для проникновения в клетку и интеграции в нить ее ДНК, наблюдая за развитием болезни среди нескольких популяций мышей, у которых были отключены гены, предположительно участвующие в процессе инфицирования.
Читайте: Мужчинам на заметку: ученые нашли "ген женской неверности"
Как объясняют ученые, заражение клетки Эболой происходит в два этапа. Сначала вирус прикрепляется к ее оболочке и ждет, пока клетка не распознает его как чужеродное тело и не попытается уничтожить, поместив вирусную частицу в лизосому. Она представляет собой пузырек с кислотами и ферментами, в котором клетки обычно уничтожают обрывки белков и прочий "био-мусор".
Когда в нее попадает вирус Эболы, он не растворяется, а цепляется, как показали эксперименты Чандрана и его коллег, за стенку лизосомы, прикрепляясь к молекулам белка NPC1, и "катапультирует" генетический материал во внешнюю среду, в цитоплазму клетки. Оттуда РНК вируса попадает в ядро клетки и начинает "штамповать" копии вирусных частиц.
Читайте: Ученые определили, когда люди смогут стать бессмертными киборгами
Блокировка даже одной копии гена, который отвечает за сборку молекул NPC1, в геноме подопытных мышей привела к тому, что грызуны начали гораздо легче переносить Эболу и частота смертности заметно снизилась. Инфекция начиналась очень бурно, но она быстро затихала, и через несколько дней после их заражения в крови больше не было следов вируса. Удаление обеих копий NPC1 сделало грызунов неуязвимыми для Эболы.
Ободренные подобными результатами, ученые попытались подавить работу этого белка, используя препараты, которые были разработаны ранее для лечения редких болезней, связанных с дисфункцией лизосом. К большому разочарованию Чандрана и его коллег, ни один препарат не возымел такого же действия, как удаление генов, и лишь два их них оказали едва заметное положительное влияние.
Читайте: Ученые определили, что для человека опаснее – жара или холод
Ранее "Обозреватель" сообщал, что в Африке вирусом Эбола уже заражены 26 тысяч человек.










